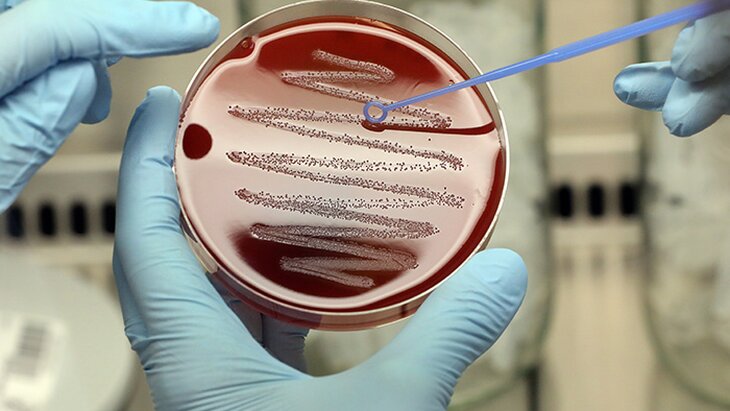

07 октября 2020, 15:45
ОбществоУченые предупредили о распространении нового штамма скарлатины
Фото: ТАСС/Wolfgang Kumm/dpa
Ученые выяснили, что вспышки скарлатины в Великобритании и Австралии вызваны новым штаммом стрептококка группы А. Итоги исследования опубликовал журнал Nature Communications.
Генетические исследования, проведенные австралийскими биологами совместно с британскими, американскими, канадскими и китайскими коллегами, позволили объяснить возрождение патогена, считавшегося побежденным.
Оказавшись в детском организме, микроб выделяет токсичные соединения – суперантигены. Это приводит к фарингиту и сыпи, может стать причиной возникновения токсического шока, приводящего к отказу жизненно важных органов. Ученые исследовали гены нового стрептококка группы А из Северо-Восточной Азии, охарактеризовав множество его суперантигенов. Среди них ученые обнаружили неизвестный ранее суперантиген: именно он, считают ученые, дает микробам "умный" способ проникновения.
По мнению биологов, причина повышенной вирулентности штамма – в независимой настройке генов, которая известна как "горизонтальный перенос": ген, который развивался в микробе, попадает в его собственный вирус, называемый фагом, где отредактированная ДНК создает своего рода клон оригинала. Этот способ адаптации не только ускоряет проникновение патогена в ткани хозяина, но и "защищает" его от антибиотиков.
Выводы исследователи проверили с помощью техники геномного редактирования, отключив кодирование определенных генов: штаммы утратили способность заражать лабораторных животных, которых использовали в экспериментах для оценки вирулентности бактерий.
Биологи сделали вывод о том, что новый штамм стрептококка группы А является более опасным, чем его побежденный родственник, поэтому необходимо срочно разрабатывать оружие для борьбы с ним.
"Стрептококк группы A, распространяющийся через аэрозоли, как и SARS-CoV-2, вряд ли вызовет эпидемию при нынешних ограничениях, – отмечает руководитель исследования, биолог Марк Уокер. – Но когда социальное дистанцирование в конечном итоге будет ослаблено, скарлатина, вероятно, вернется".
Скарлатина – инфекционная болезнь, которую вызывает гемолитический стрептококк группы А Streptococcus pyogenes. К 1940-м годам заболевание было практически ликвидировано благодаря появлению антибиотиков, однако в 2014 году вспышку зафиксировали в Великобритании, а теперь – в Австралии. Главными симптомами болезни являются боль в горле, лихорадка, головная боль, опухшие лимфоузлы и характерная красная сыпь.
Ранее врач рассказала, что делать при появлении симптомов ОРВИ.
В России провели более 48 миллионов тестов на COVID-19








Собянин назвал самые популярные площадки проекта "Учебный день в музее"



























